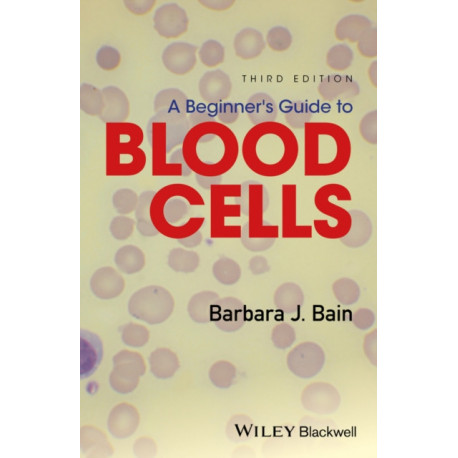
A Beginner's Guide to Blood Cells

Kurv
Vare
varer
(tom)
Ingen varer
Fastlægges senere
Forsendelse
0,- kr
I alt
A Beginner's Guide to Blood Cells
(Bog, Paperback / softback, Engelsk)
Forlag:
John Wiley and Sons Ltd
- Type: Bog
- Format: Paperback / softback
-
Sprog:
Engelsk

- ISBN-13: 9781119367734
- Se flere detaljer ▼
Bemærk: Kan ikke leveres før jul.
Beskrivelse
The third edition of this popular pocket book, A Beginner s Guide to Blood Cells written by Professor Barbara Bain, provides a concise introduction to normal and abnormal blood cells and blood counts for trainees in haematology.
Læsernes anmeldelser (0)
Alle detaljer
| Forlag | John Wiley and Sons Ltd |
| Forfatter | Barbara J. (St Mary's Hospital Bain |
| Type | Bog |
| Format | Paperback / softback |
| Sprog | Engelsk |
| Udgave | 3 ed |
| Udgivelsesdato | 19-05-2017 |
| Første udgivelsesår | 2017 |
| Originalsprog | United Kingdom |
| Sideantal | 160 |
| Indbinding | Paperback / softback |
| Forlag | John Wiley and Sons Ltd |
| Sideoplysninger | 160 pages |
| Mål | 141 x 214 x 12 |
| ISBN-13 / EAN-13 | 9781119367734 |

